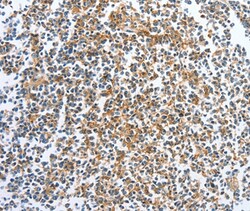

Promotional price valid on web orders only. Your contract pricing may differ. Interested in signing up for a dedicated account number?
Learn More
Learn More
Invitrogen™ CKAP2 Polyclonal Antibody


Rabbit Polyclonal Antibody
Supplier: Invitrogen™ PA550381
Description
The antibody detects endogenous levels of total CKAP2 protein.
Nedd4-binding partner-1 (N4BP1) is a developmentally expressed protein interactor and monoubiquitylation substrate of Nedd4, a HECT domain-containing ubiquitin ligase that mediates ubiquitylation and proteasome degradation of target proteins and may have a fundamental role to play in embryonic processes. N4BP1 can undergo Nedd4-mediated polyubiquitylation and proteosomal degradation. N4BP1 also functions as a negative regulator of AIF4 (also known as ITCH or Atrophin-1), an E3-ubiquitin ligase, by interacting with the second WW domain of AIF4 and impairing ubiquitination of substrates.
Specifications
| CKAP2 | |
| Polyclonal | |
| Unconjugated | |
| CKAP2 | |
| AI461656; AW228814; Ckap2; CTCL tumor antigen se20-10; cytoskeleton associated protein 2; cytoskeleton-associated protein 2; LB1; se20-10; TMAP; Tumor- and microtubule-associated protein; tumor-associated microtubule-associated protein | |
| Rabbit | |
| Antigen affinity chromatography | |
| RUO | |
| 26586 | |
| -20°C | |
| Liquid |
| Immunohistochemistry (Paraffin) | |
| 2.9 mg/mL | |
| PBS with 40% glycerol and 0.05% sodium azide; pH 7.4 | |
| Q8WWK9 | |
| CKAP2 | |
| Full length fusion protein of Human CKAP2. | |
| 100 μL | |
| Primary | |
| Human | |
| Antibody | |
| IgG |
Product Content Correction
Your input is important to us. Please complete this form to provide feedback related to the content on this product.
Product Title
Spot an opportunity for improvement?Share a Content Correction